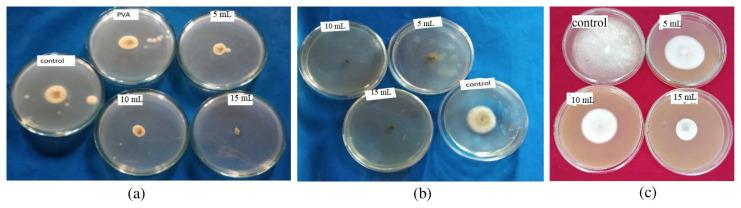
https://cdn.ncbi.nlm.nih.gov/pmc/blobs/bf8b/10446923/c369213c4b3d/turkjchem-46-6-1984f13.jpg

聚乙烯醇-蛇床子素复合膜的合成、表征及抗菌性能评价
Synthesis, characterization, and antimicrobial evaluation of polyvinylalcohol-osthol composite films.
作者信息
Gowsia Ishrat, Mir Feroz A, Banday Javid A
机构信息
Department of Chemistry, Natural Product Research Lab, National Institute of Technology Srinagar, Srinagar, India.
Department of Physics, Baba Ghulam Shah Badshah University Rajouri, Rajouri, India.
出版信息
Turk J Chem. 2022 Aug 30;46(6):1984-1998. doi: 10.55730/1300-0527.3496. eCollection 2022.
Although poly-vinyl alcohol (PVA) has certain mechanical drawbacks such as a weak barrier, it has widely been used in food packaging over the last many years. To increase the suitability of PVA (CHO) and render it ideal for food packaging, a diversity of studies have already been carried out. In the below-mentioned script, we, for the first time, report the use of natural product osthol in making a new composite with PVA for enhancing thermal, physicochemical, and antimicrobial properties. The significant aim of the report is the insertion of osthol (CHO) into PVA polymer, which is to be subsequently used for antimicrobial applications. The synthesis of the polymer composite film is done by solvent casting method and is characterized by SEM, XRD, FT-IR, and UV-Vis spectroscopy analysis. The manifestation of antimicrobial activity against () (ATCC8738P), (ATCC8739), , , and by the film composite is remarkable. The addition of osthol molecule increases the tensile strength of PVA films from 18.73 ± 0.56 Mpa (PVA) to 24.58 ± 0.49 Mpa (15 mL). As a result, tensile strength increases by 23.79% in a film containing a higher concentration of osthol (15 mL). The barrier properties of PVA osthol composite films improve with the incorporation of osthol. OTR and WVTR decrease by 43.03% and 30.24%, respectively, on the addition of 15 mL osthol. Reduction in OTR and WVTR of the films could increase their applicability in the food sector. An increase in contact angle from 43° (pure PVA) to 66.7° increases the hydrophobic character of the composite films which is desirable for food packaging. This noticeable enhancement of the properties of the PVA film like hydrophobicity, mechanical, barrier, and antimicrobial is supporting the potential application of achieved material in packaging of easily perishable foods like fruits and vegetables by extending their shelf life.
尽管聚乙烯醇(PVA)存在某些机械方面的缺点,如阻隔性较弱,但在过去许多年里它已广泛应用于食品包装。为提高PVA(CHO)的适用性并使其成为理想的食品包装材料,已经开展了多种研究。在下文所述内容中,我们首次报道了使用天然产物蛇床子素与PVA制备新型复合材料以增强其热性能、物理化学性能和抗菌性能。本报告的重要目的是将蛇床子素(CHO)引入PVA聚合物中,随后将其用于抗菌应用。聚合物复合膜通过溶液浇铸法合成,并通过扫描电子显微镜(SEM)、X射线衍射(XRD)、傅里叶变换红外光谱(FT-IR)和紫外可见光谱分析进行表征。该薄膜复合材料对()(ATCC8738P)、(ATCC8739)、、、和的抗菌活性表现显著。蛇床子素分子的添加使PVA薄膜的拉伸强度从18.73±0.56兆帕(PVA)提高到24.58±0.49兆帕(15毫升)。因此,在含有较高浓度蛇床子素(15毫升)的薄膜中,拉伸强度提高了23.79%。PVA-蛇床子素复合膜的阻隔性能随着蛇床子素的加入而改善。添加15毫升蛇床子素后,氧气透过率(OTR)和水蒸气透过率(WVTR)分别降低了43.03%和30.24%。薄膜OTR和WVTR的降低可提高其在食品领域的适用性。接触角从43°(纯PVA)增加到66.7°,增加了复合膜的疏水性,这对于食品包装是有利的。PVA薄膜在疏水性、机械性能、阻隔性能和抗菌性能等方面的显著增强,支持了所制备材料在包装水果和蔬菜等易腐食品方面的潜在应用,可延长其保质期。